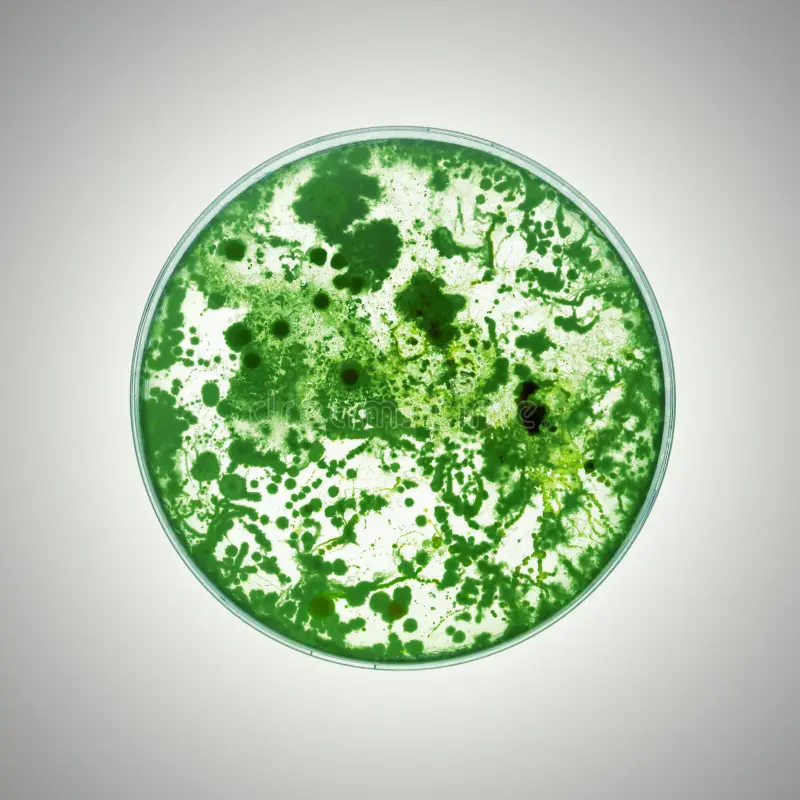
Go Werks Pro Microbial Cleaning

Microbial Testing for a Healthier Home Environment
What truly sets Go Werks Pro apart from other carpet cleaning companies is our passion for service and our deep commitment to the health and safety of our clients. In addition to our powerful cleaning techniques, Go Werks Pro offers microbial testing, a service that helps identify and understand the microbes, bacteria, mold, and pathogens present in your carpets. Many people don’t realize that carpets can harbor a variety of harmful microorganisms that can negatively impact their health. Whether its mold growth in damp conditions or the accumulation of bacteria that can cause unpleasant odors and allergies, microbial contamination is a serious concern for homeowners and businesses alike.
Go Werks Pro’s microbial testing involves collecting samples from your carpet and analyzing them onsite and in our lab to identify any dangerous pathogens or mold. Once the results are available, Go Werks Pro can recommend a cleaning solution that specifically targets the identified issues, ensuring that the cleaning process addresses your carpet’s unique needs. Whether its treating mold growth, removing bacteria, or eliminating allergens, this testing provides peace of mind knowing that your carpets are not just clean, but safe and free from harmful microbes. Learn more about our microbial testing here.